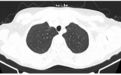
CT 提示肺结节 5 mm，手术还是观察？ 这 6 张表给出答案

随着人们防癌观念的加强以及低剂量胸部 CT 筛查的普及,越来越多的肺结节被发现,那么,发现了肺结节该怎么办呢?这不,刚退休 2 年的王女士就遇见了这样头疼的问题。王女士以往体检都选择的胸片,最近听说周围好多熟人和朋友都有肺结节,有的甚至还是早期肺癌,做了手术。
因为担心,王女士今年的例行体检果断选择了胸部 CT,结果发现右肺上叶尖后段胸膜下磨玻璃结节影(0.6 cm × 0.5 cm)(见图 1),她无吸烟史,没有肿瘤家族史,下一步她该怎么办呢?手术还是随访观察?
图 1
新发现的肺结节手术还是随访,该从哪几个方面考虑?如何随访观察?
(一)肺部结节究竟是手术还是随访,首先要确定肺结节是否为高危结节,以及恶性概率的高低。主要包括以下几种手段:
1. 临床信息:包括年龄、职业、吸烟史、慢性肺部疾病史、个人和家族肿瘤史、治疗经过及转归。
通过临床信息评估,患者存在肺癌的高危险因素包括:① 吸烟:吸烟 ≥ 20 年包,或曾吸烟 ≥ 20 年包戒烟<15 年;② 二手烟或环境油烟吸入史;③ 职业致癌物质暴露史:长期接触氡、砷、铍、铬、镉、石棉、二氧化硅等;④ 个人肿瘤史;⑤ 直系亲属肺癌家族史;⑥ 慢性肺部疾病史:慢性阻塞性肺疾病、肺结核和肺纤维化等。
2. 影像学检查:最常用的就是胸部 CT,包括以下几个方面:
1)外观评估:
① 结节大小:随着肺结节体积增大,其恶性概率随之增加;
② 结节形态:大多数恶性结节形态为圆形或类圆形;
③ 结节边缘:恶性结节多呈分叶状,或有毛刺征、胸膜凹陷征或血管集束征;
④ 结节-肺界面:恶性肺结节边缘多清楚但不光整,甚至有毛刺。
总结就是「分叶、毛刺、胸膜凹陷征」是恶性病变的特点,但小结节中的早期肺癌上述特征不明显,需结合内部特征。
2)内部特征:
① 密度:纯磨玻璃结节影,尤其小于 5 mm 的,常提示不典型腺瘤样增生;部分实性结节,实性成分超过 50% 常提示恶性可能性大;持续存在的磨玻璃结节大多数为恶性或有向恶性发展的倾向;CT 值高则恶性概率大,反之则恶性概率小;
② 结构:支气管被包埋且伴局部管壁增厚,或包埋的支气管管腔不规则,则恶性可能性大。
3)随访过程中出现以下变化时,应考虑为恶性:
① 直径增大,倍增时间符合肿瘤生长规律;
② 病灶稳定或增大,并出现亚实性、实性成分,所占比重有增加趋势,动态测量结节 CT 值有增加趋势;
③ 病灶缩小,但出现实性成分或实性成分增加;
④ 血管生成符合恶性肺结节规律,如血管穿行;
⑤出现分叶、毛刺和或胸膜凹陷征。
3. 肿瘤标志物:临床常用的有胃泌素释放肽前体、神经特异性烯醇化酶,对小细胞肺癌的诊断有协助作用;肺腺癌常有癌胚抗原增高;肺鳞癌常有鳞状细胞癌抗原增高;细胞角蛋白片段 19 对肺鳞癌的诊断有一定的参考意义,部分肺腺癌患者也会出现增高。
4. 功能显像:PET-CT 用于不能定性的直径大于 8 mm 的实性结节以区分其良恶性,标准化摄取值(SUV)为其重要参数,当 SUV 值大于 2.5 时,恶性肿瘤可能性比较大。PET-CT 对诊断恶性肺结节的敏感度为 72% ~ 94%。此外,PET-CT 还有一个功能,那就是为选择穿刺活检部位提供重要参考和依据。
5. 非手术活检:
1)气管镜检查:常规包括直视下刷检、活检、经支气管镜肺活检、支气管肺泡灌洗获取细胞学或组织学诊断;其他包括自荧光支气管镜、支气管内超声引导下肺活检、虚拟导航气管镜、电磁导航气管镜等;
2)经胸壁肺穿刺活检术:可在 CT 或超声引导下进行。
6. 手术活检:胸腔镜检查、纵膈镜检查。
据上述评估手段对肺部结节行肺恶性肿瘤概率评估(见表 1)
(二)据肺结节大小、密度、恶性概率等因素进一步制定诊疗计划:
1. 孤立实性结节:
① 8 mm ~ 30 mm 实性结节:(见图 2)
图 2. 8 mm ~ 30 mm 实性结节管理流程
② ≤ 8 mm 实性结节(见表 2):
2. 孤立亚实性结节(见表 3):
3. 多发结节(见表 4、表 5):
总结
临床上,尽管肺结节的评估手段是多元化的,包括病史、影像学检查、肿瘤标志物检查、功能显像以及一些有创检查和手术,但临床上医生最可及的是病史、胸部 CT,部分医院可完成肿瘤标志物检查,费用在几百元不等,有一定参考价值。但对于 PET-CT,因其费用较高,作为常规评估比较困难。有创的评估检查手段主要是针对前面几种方式综合评估为高危的患者所采取的方法,临床普及性不强。
因此,肺部结节究竟是手术还是随访,如何进行随访重点在于病史和胸部 CT,综合评估肺结节恶性概率、结节大小、密度、是单发还是多发等多种因素,制定个体化治疗及随访方案。
本文首发于丁香园旗下专业平台:丁香园呼吸时间
作者:重庆大学附属肿瘤医院 罗玲、田艺
编辑:美超
“特别声明:以上作品内容(包括在内的视频、图片或音频)为凤凰网旗下自媒体平台“大风号”用户上传并发布,本平台仅提供信息存储空间服务。
Notice: The content above (including the videos, pictures and audios if any) is uploaded and posted by the user of Dafeng Hao, which is a social media platform and merely provides information storage space services.”